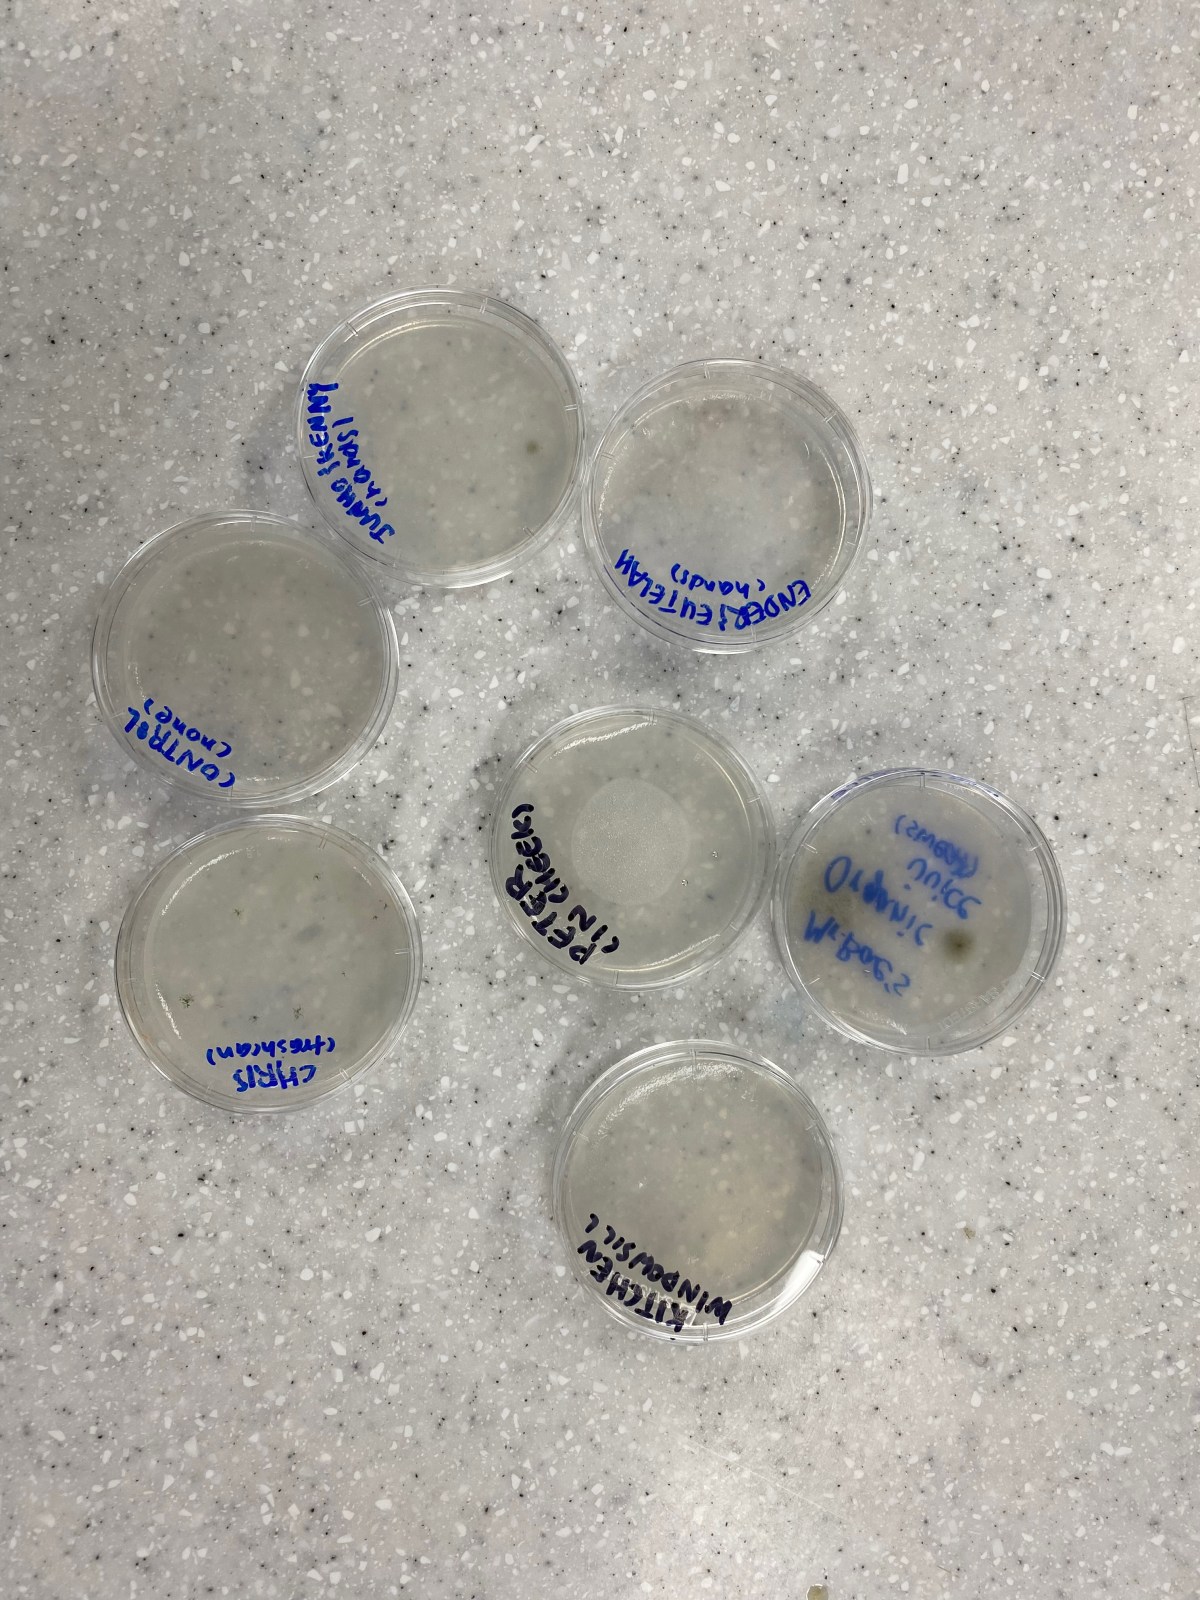
ES Summer Camp Day 13&nbsp;(6/29/22)

Chemical Commonly Found in Dry Cleaning Causing Parkinson’s Disease
According to a study published in the Journal of Parkinson’s Disease by an international team of scientists (Ray et. al), a chemical commonly utilized in dry cleaning, metal degreasing and decaffeination of coffee has been identified as a possible…
Read More
Symbiosis.. Or is it really?
While researching about the different interactions that exist in the Amazonian rainforest for an Environmental Science Biomes project, I came across the “symbiotic” relationship between lycaenid species caterpillars and cocktail ants. (1) The Amazon rainforest is a crucial biome…
Read More
ACS Chem Club Has a Blast at the School Carnival
A few weeks ago, ACS members were fortunate enough to host their own booth for the all-school carnival held in years post-COVID. Through weeks of busy brainstorming with the team, our club eventually came to the consensus to host…
Read More
ES Summer Camp Day 13 (6/29/22)
Bacteria cultivation time! Today’s lesson was kind of nostalgic in the sense that it reminded me of my CRISPR experiments, when I failed to successfully create the perfect agar petri dishes. I remember when I accidentally over-microwaved my glass…
Read More
ES Summer Camp Day 12 (6/28/22)
*Mild flashbacks to my AP Chemistry video project on the exact same experiment..* Prepare yourselves for an ACIDIC adventure! Today’s class was about exploring acidities of different household liquids and beverages we commonly enjoy or use through a natural…
Read More
ES Summer Camp Day 11 (6/27/22)
Different gases have different densities. Though we learn in Elementary school that we only exhale carbon dioxide, that claim is partially true. The air we exhale is composed of a variety of different gases, including carbon dioxide, so its…
Read More
ES Summer Camp Day 9 (6/23/22)
Throwback to mini me in 5th grade struggling to measure the length of the food coloring pathway on my celery for my science fair project. This lesson plan was inspired by that science project, actually. If yesterday’s class lesson…
Read More
ES Summer Camp Day 8 (6/22/22)
Finally our first experiment for the lower division students! Yesterday, the students decorated their science notebooks. While planning the experiments and lesson plans for the lower division students, who were younger than the upper division students, I often contemplated…
Read MoreSomething went wrong. Please refresh the page and/or try again.